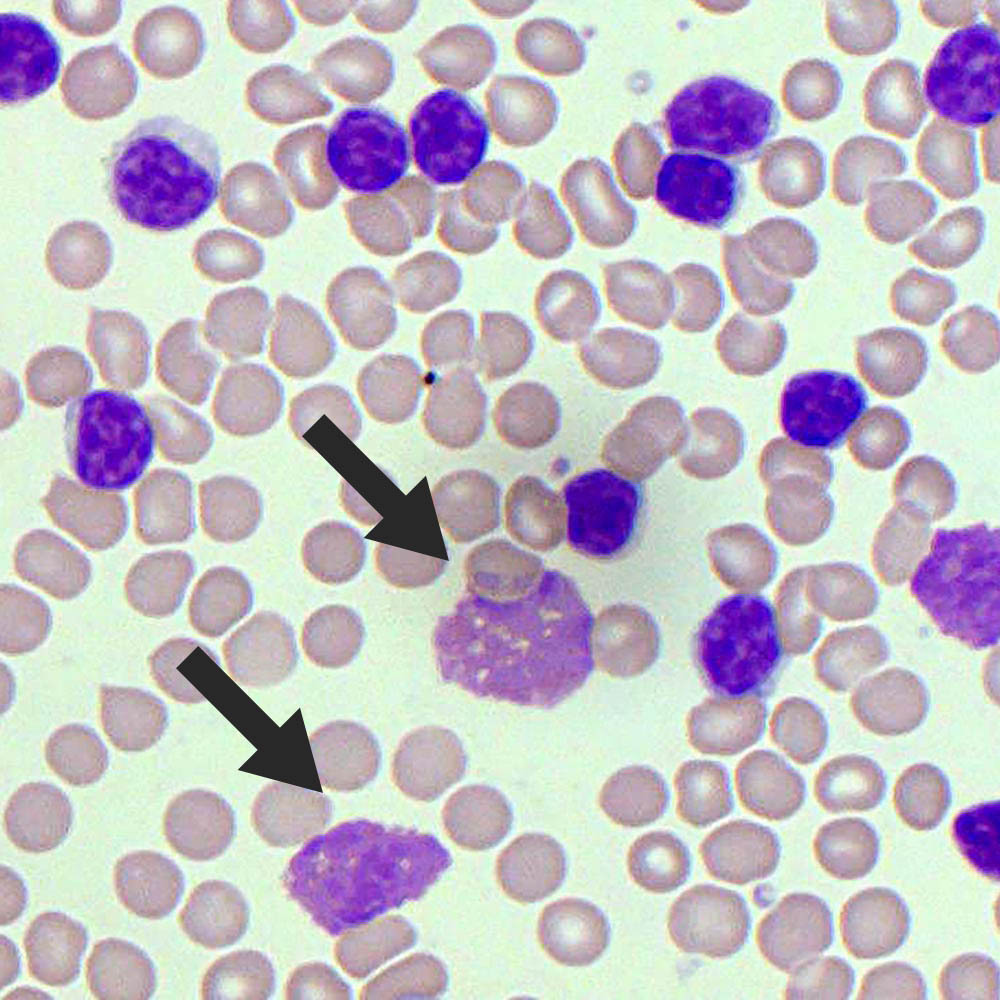

Describe what is meant by the pathology leukaemia [3]
Leukaemia is cancer of a particular line of stem cells in the bone marrow, causing unregulated production of a specific type of blood cell.
A genetic mutation in one of the precursor cells in the bone marrow leads to excessive production of a single type of abnormal white blood cell.
This can result in pancytopenia, which is a combination of low red blood cells (anaemia), white blood cells (leukopenia) and platelets (thrombocytopenia).
State the 4 classifications of leukaemia [4]
Acute myeloid leukaemia (rapidly progressing cancer of the myeloid cell line)
Acute lymphoblastic leukaemia (rapidly progressing cancer of the lymphoid cell line)
Chronic myeloid leukaemia (slowly progressing cancer of the myeloid cell line)
Chronic lymphocytic leukaemia (slowly progressing cancer of the lymphoid cell line)
Which of the following is most associated with smudge cells
Acute myeloid leukaemia
Acute lymphoblastic leukaemia
Chronic myeloid leukaemia
Chronic lymphocytic leukaemia
Chronic lymphocytic leukaemia
Which of the following is most associated with warm haemolytic anaemia
Acute myeloid leukaemia
Acute lymphoblastic leukaemia
Chronic myeloid leukaemia
Chronic lymphocytic leukaemia
Which of the following is most associated with warm haemolytic anaemia
Chronic lymphocytic leukaemia
Warm hemolytic anemia is a type of autoimmune hemolytic anemia (AIHA), which is a condition where the body’s immune system attacks and destroys its own red blood cells123. Warm hemolytic anemia is caused by IgG antibodies that bind red blood cells at normal body temperature12. The diagnosis is confirmed by the direct antiglobulin (direct Coombs) test1.
Which of the following is most associated with : exposure to certain toxins (e.g. benzene and organochlorine insecticides)
Acute myeloid leukaemia
Acute lymphoblastic leukaemia
Chronic myeloid leukaemia
Chronic lymphocytic leukaemia
Which of the following is most associated with : exposure to certain toxins (e.g. benzene and organochlorine insecticides)
Acute myeloid leukaemia
Acute lymphoblastic leukaemia
Chronic myeloid leukaemia
Chronic lymphocytic leukaemia
Which of the following is most associated with Downs syndrome
Acute myeloid leukaemia
Acute lymphoblastic leukaemia
Chronic myeloid leukaemia
Chronic lymphocytic leukaemia
Which of the following is most associated with Downs syndrome
Acute myeloid leukaemia
Acute lymphoblastic leukaemia
Chronic myeloid leukaemia
Chronic lymphocytic leukaemia
Which of the following is most associated with : exposure to previous chemotherapy regimens, in particular alkylating agents and topoisomerase-II inhibitors
Acute myeloid leukaemia
Acute lymphoblastic leukaemia
Chronic myeloid leukaemia
Chronic lymphocytic leukaemia
Acute myeloid leukaemia
Which of the following is most associated with Fanconi anaemia
Acute myeloid leukaemia
Acute lymphoblastic leukaemia
Chronic myeloid leukaemia
Chronic lymphocytic leukaemia
Acute myeloid leukaemia
Which of the following is most associated with the Philadelphia chromosome
Acute myeloid leukaemia
Acute lymphoblastic leukaemia
Chronic myeloid leukaemia
Chronic lymphocytic leukaemia
Which of the following is most associated with the Philadelphia chromosome
Acute myeloid leukaemia
Acute lymphoblastic leukaemia
Chronic myeloid leukaemia
Chronic lymphocytic leukaemia
Which of the following is most associated with three phases
Acute myeloid leukaemia
Acute lymphoblastic leukaemia
Chronic myeloid leukaemia
Chronic lymphocytic leukaemia
Which of the following is most associated with three phases
Acute myeloid leukaemia
Acute lymphoblastic leukaemia
Chronic myeloid leukaemia
Chronic lymphocytic leukaemia
Which of the following is most associated with Auer rods
Acute myeloid leukaemia
Acute lymphoblastic leukaemia
Chronic myeloid leukaemia
Chronic lymphocytic leukaemia
Which of the following is most associated with Auer rods
Acute myeloid leukaemia
Acute lymphoblastic leukaemia
Chronic myeloid leukaemia
Chronic lymphocytic leukaemia
Which of the following is most likely this imaging?
Acute myeloid leukaemia
Acute lymphoblastic leukaemia
Chronic myeloid leukaemia
Chronic lymphocytic leukaemia

Auer rods
Acute myeloid leukaemia
Acute lymphoblastic leukaemia
Chronic myeloid leukaemia
Chronic lymphocytic leukaemia
Which of the following is most likely to have a transformatong into a rare type of non-Hodgkin lymphoma, usually diffuse large B cell lymphoma?
Acute myeloid leukaemia
Acute lymphoblastic leukaemia
Chronic myeloid leukaemia
Chronic lymphocytic leukaemia
Chronic lymphocytic leukaemia = Richter’s transformation
Which of the following is most associated with presenting in children
Acute myeloid leukaemia
Acute lymphoblastic leukaemia
Chronic myeloid leukaemia
Chronic lymphocytic leukaemia
Which of the following is most associated with presenting in children
Acute myeloid leukaemia
Acute lymphoblastic leukaemia
Chronic myeloid leukaemia
Chronic lymphocytic leukaemia
Describe the presentation of leukaemia (in general) [+]
Fatigue
Fever
Pallor due to anaemia
Petechiae or bruising due to thrombocytopenia:
Abnormal bleeding
Lymphadenopathy
Hepatosplenomegaly
Failure to thrive (children)
What is a key presenting feature of leukaemia? [1]
Describe this feature [1]
One key presenting feature of leukaemia is bleeding under the skin due to thrombocytopenia. Bleeding under the skin causes non-blanching lesions. These lesions are called different things based on the size of the lesions:
- Petechiae
- Purpura
- Eccyhmosis
One key presenting feature of leukaemia is []
Bleeding under the skin causes non-blanching lesions. These lesions are called different things based on the size of the lesions:
Describe the difference between the following: [3]
- Petechiae
- Purpura
- Eccyhmosis
Petechiae are less than 3 and caused by burst capillaries
Purpura are 3 – 10mm
Ecchymosis is larger than 1cm
The NICE guidelines on suspected cancer (2021) recommend a full blood count within 48 hours for patients with suspected leukaemia.
They recommend children or young people with [] or [] are sent for immediate specialist assessment.
The NICE guidelines on suspected cancer (2021) recommend a full blood count within 48 hours for patients with suspected leukaemia.
They recommend children or young people with petechiae or hepatosplenomegaly are sent for immediate specialist assessment.
Which of the following is used for the definitive diagnosis of leukaemia?
Full blood count
Blood film
Bone marrow biopsy
CT or PET scans
Lymph node biopsy
Bone marrow biopsy - used to analyse the cells in the bone marrow to establish a definitive diagnosis of leukaemia.
Which part of the body is a bone marrow biopsy typically taken from for leukaemia diagnosis? [1]
What are the two methods? [2]
Iliac crest
Bone marrow aspiration
- involves taking a liquid sample of cells from within the bone marrow.
Bone marrow trephine
- involves taking a solid core sample of the bone marrow and provides a better assessment of the cells and structure.
Describe 5 risk factors that increase the risk of AML [4]
Congenital disorders:
- Congenital neutropenia
- Fanconi anaemia
Radiation exposure
Myeloproliferative disorders:
- polycythaemia ruby vera
- myelofibrosis
Previous chemotherapy:
- Alkylating agents
- topoisomerase-II inhibitors
Toxins
- Insecticides
Desribe the typical presentation of a patient with AML [8]
Features are largely related to bone marrow failure:
- anaemia (fatigue; pallor; angina)
- fever (due to infections)
- splenomegaly & hepatomegaly
- recurrent infections (neutropenia)
- thrombocytopenia (petechiae; nose bleeds; bruising; ecchymosis; gingivial bleeding)
- bone pain (sternal discomfort; aching in extremities)
- leukaemia cutis (nodular, violaceous lesions on the skin)
- gingivial hypertrophy
- CNS involvement: headaches; visual changes; nerve palsies
State potential features of AML if it has spread and caused tissue involvemment [4]
- Lymphadenopathy
- Hepatosplenomegaly
- Bone pain
- Gum hypertrophy
- Violaceous skin deposits
- Testicular enlargement
What investigation mode is required for the diagnosis of AML [1]
What finding would indicate a positive result? [1]
Bone marrow aspirate and biopsy is required for formal diagnosis of AML
≥ 20% myeloblasts in the bone marrow confirm the diagnosis




